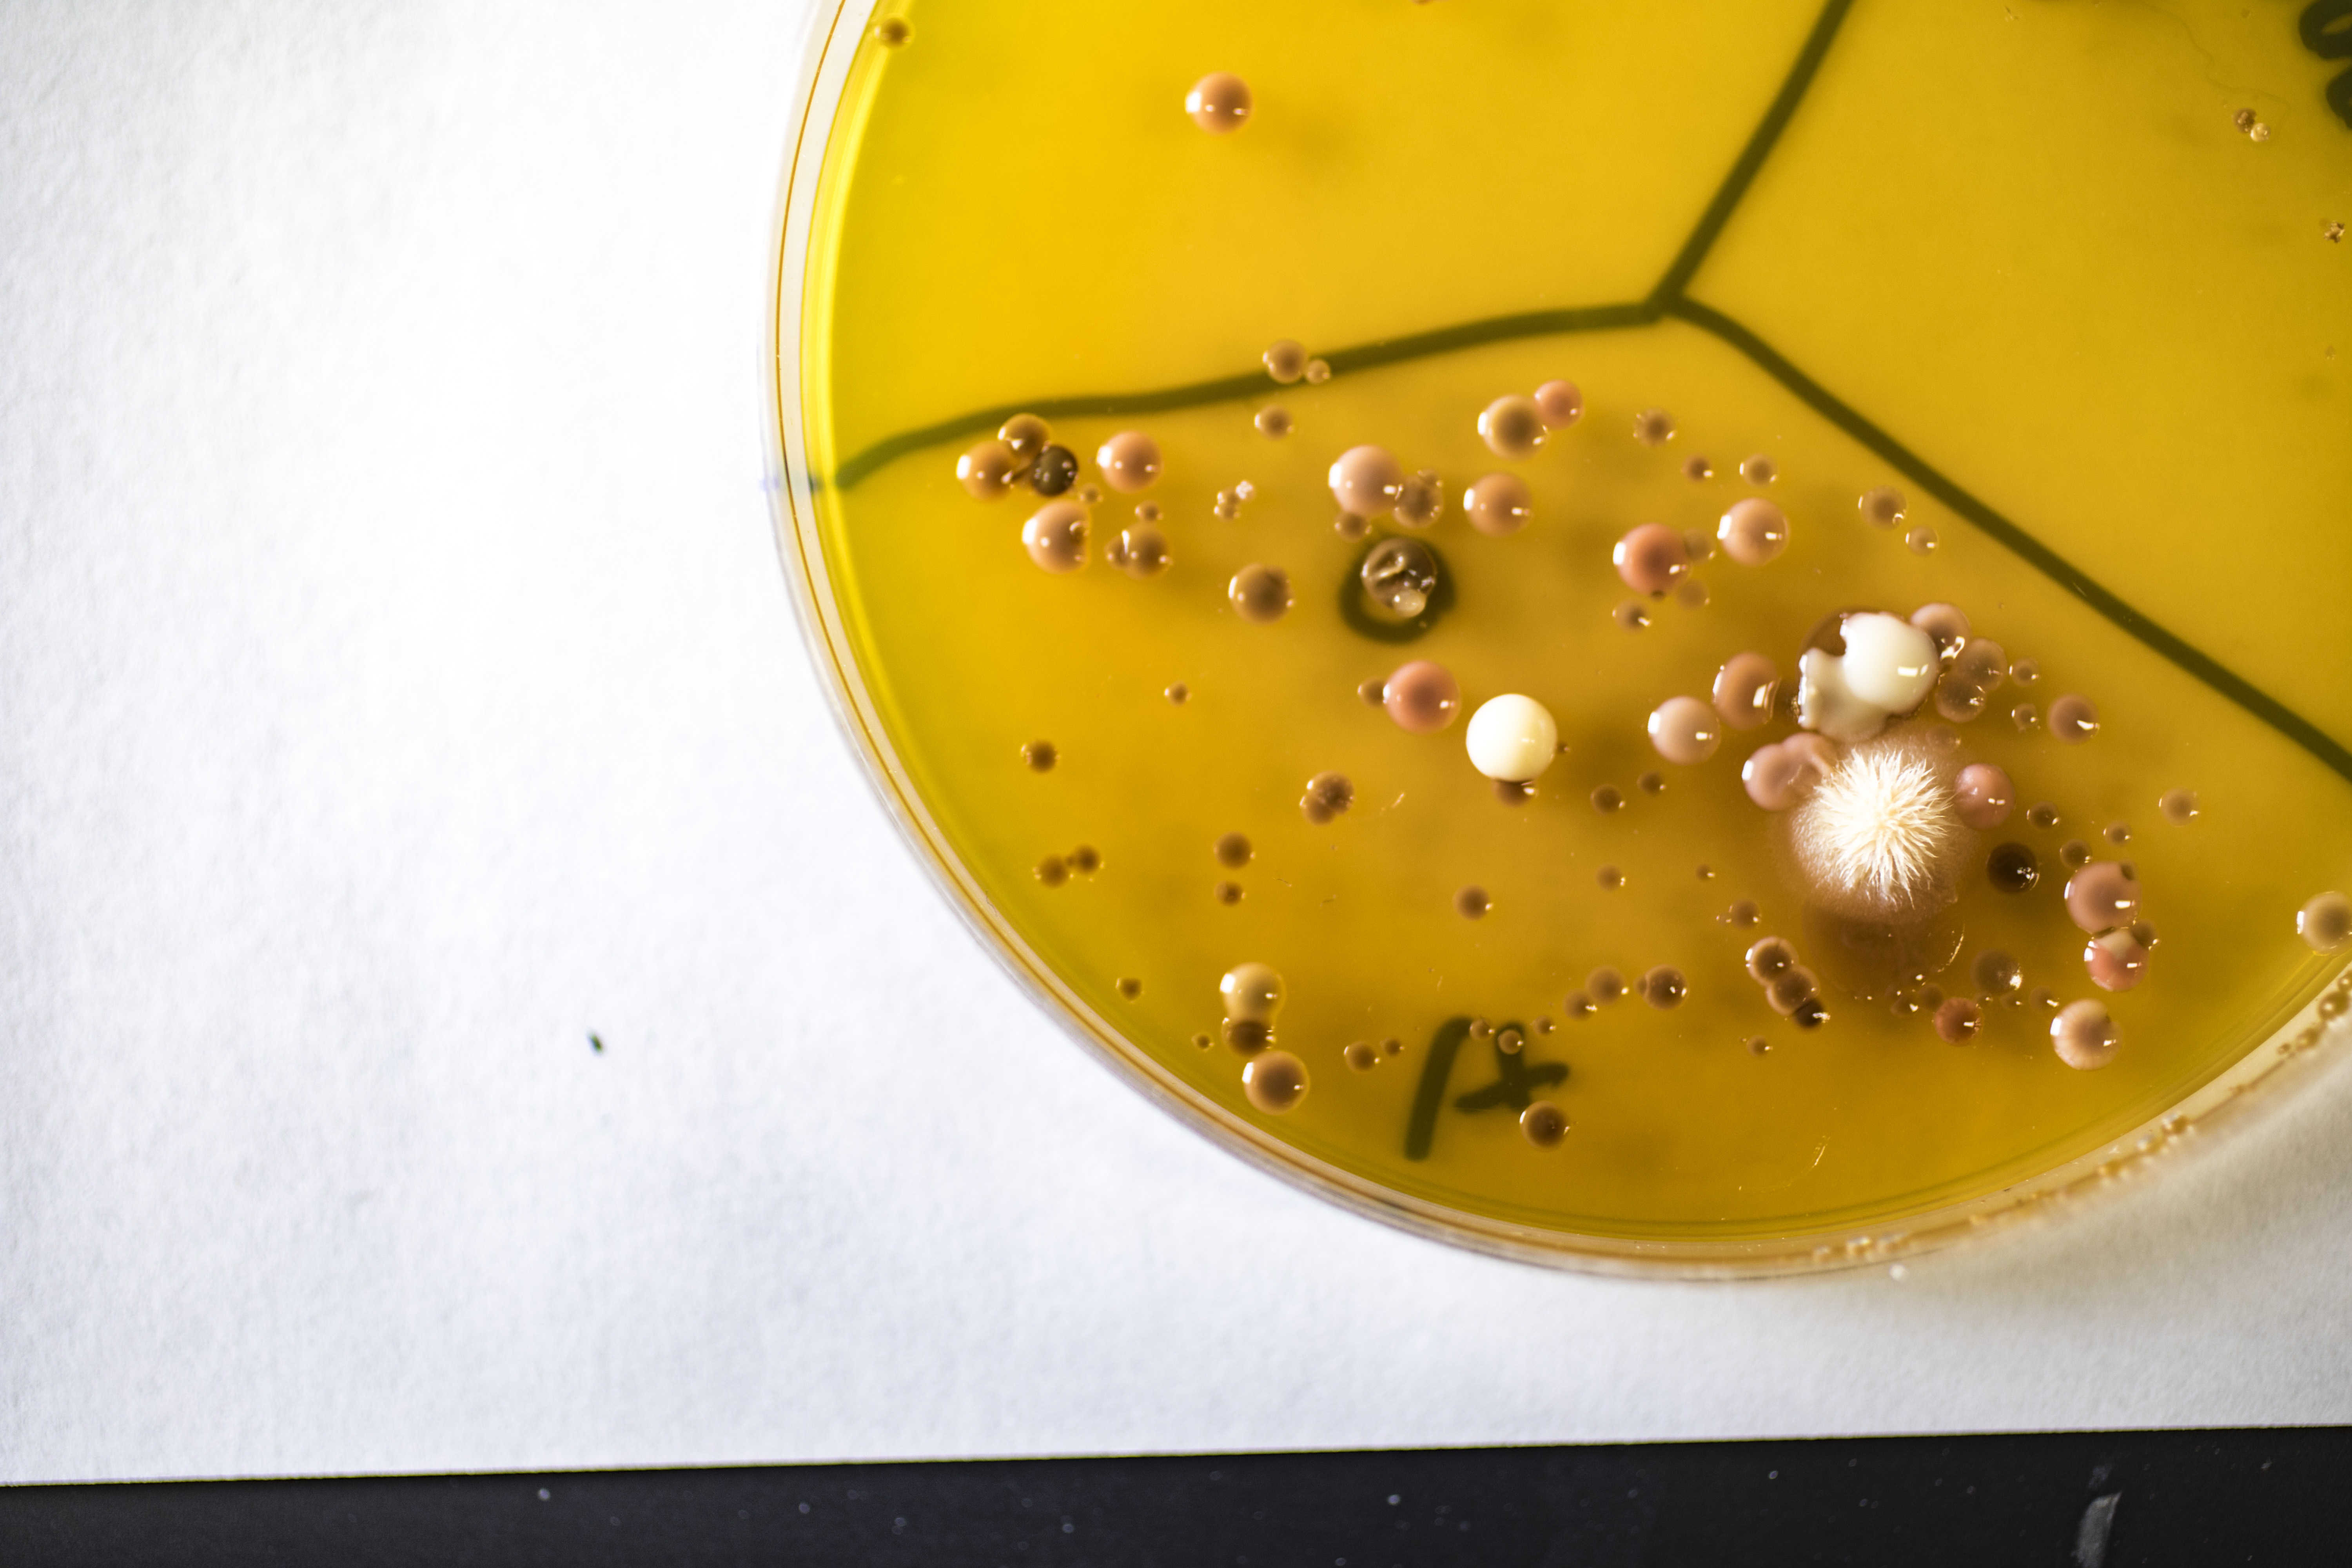
mold petri dish

Laboratory Safety

Chemical Hygiene Plan
The principal focus of the WPI Chemical Hygiene Plan (CHP) is to establish policy and procedure capable of protecting laboratory workers from health hazards associated with hazardous chemicals and to keep exposures below the Permissible Exposure Levels (PEL), as published and enforced by OSHA as a legal standard.

Exposure Control Plan for Occupational Exposure to Bloodborne Pathogens
The purpose of this Exposure Control Plan is to establish a system that will assure that all employees who have potential contact with human blood/body fluids are protected from infectious agents. The plan is intended to reduce the risk of employees who may have occupational exposure with human blood and other potentially infectious materials during the performance of their duties.
Bunsen Burner Safety Guidelines
Bunsen burners present fire hazards. They produce an open flame and burn at a high temperature, and as a result, there is potential for an accident to occur. For the safety and convenience of everyone working in a laboratory, it is important that the following guidelines be observed. In case of a fire, activate the nearest fire alarm pull station, notify all lab personnel, and evacuate the building.
Questions about mold?
This plan presents guidelines for the prevention and remediation/cleanup of mold and moisture problems in facilities at WPI, including measures designed to protect the health of building occupants and remediation workers.